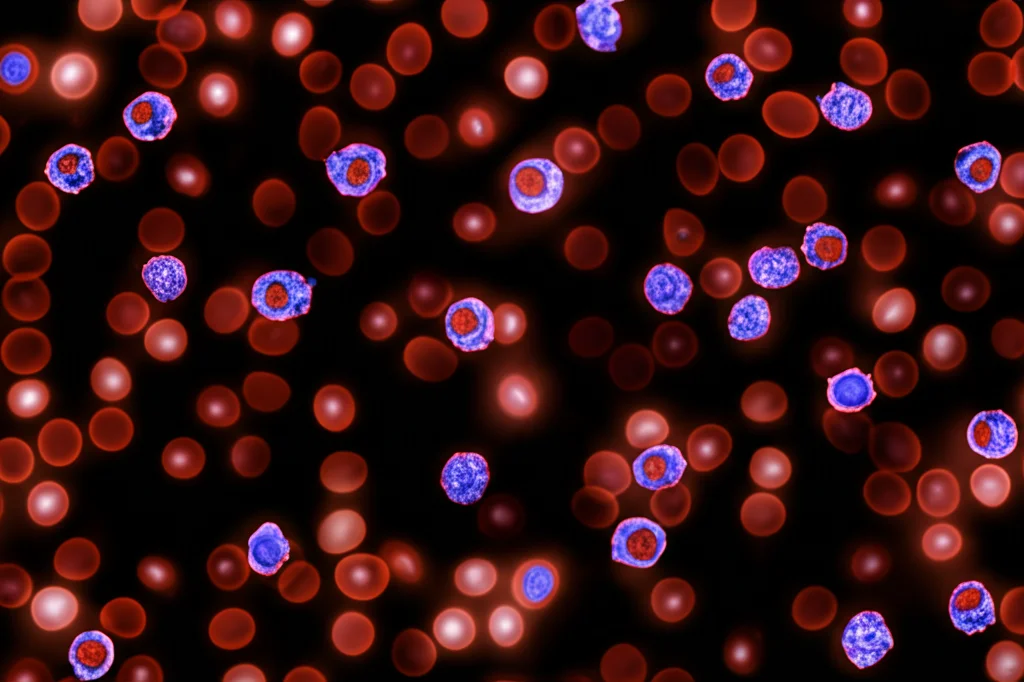
Macro fotografia, lente 90mm, alto dettaglio, illuminazione controllata, che mostra vari tipi di linfociti umani (cellule T, cellule B, cellule NK) sottilmente evidenziati in diversi colori su sfondo scuro, rappresentando un'analisi del campione di sangue.

Fegato Grasso? Ti spiego come cambiano le tue difese immunitarie nel sangue!
Ciao a tutti! Oggi voglio parlarvi di un argomento che mi sta molto a cuore e che, ahimè, riguarda sempre più persone: la steatosi epatica, comunemente nota come “fegato grasso”. Sappiamo che è legata a uno stile di vita magari non proprio impeccabile e a problemi metabolici, ma vi siete mai chiesti se e come influenzi il nostro sistema immunitario, quello che ci difende ogni giorno? Beh, io sì, e ho voluto vederci chiaro!
Negli ultimi anni, la ricerca ha evidenziato come molte malattie croniche, inclusa la steatosi, siano associate a un’infiammazione cronica di basso grado. È come se il nostro corpo fosse costantemente “un po’ acceso”, e questo, a lungo andare, non fa bene. Il sistema immunitario, in particolare i nostri soldatini, i linfociti, sono in prima linea in questa battaglia silenziosa. Misurare come cambiano questi linfociti può darci indizi preziosi sullo stato di salute generale e magari aiutarci a identificare chi è più a rischio.
Grazie a tecniche sofisticate come la citometria a flusso, oggi possiamo distinguere i vari tipi di linfociti nel sangue:
- Linfociti T (i registi della risposta immunitaria, divisi in T helper CD4+ e T citotossici CD8+)
- Linfociti B (i produttori di anticorpi)
- Cellule Natural Killer (NK) (i killer di cellule infette o tumorali)
E non finisce qui! Possiamo ulteriormente suddividere i linfociti T in base alla loro funzione (es. quelli con CD28+), al loro stato di attivazione (CD38+), se sono “nuovi” (naïve, CD45RA+CD62L+) o se hanno già combattuto (memoria, CD45RA−). Insomma, un vero esercito specializzato!
Cosa abbiamo scoperto scavando nei dati?
Considerando che in Cina la prevalenza della steatosi è schizzata quasi al 30% (un dato impressionante!), e che ormai si parla di MAFLD (Malattia Epatica Grassa Associata a Disfunzione Metabolica) proprio per sottolineare il legame stretto tra fegato e metabolismo, ho pensato fosse cruciale capire cosa succede ai linfociti nel sangue periferico di chi ha questa condizione.
Ho analizzato retrospettivamente i dati di oltre 5000 persone che si erano sottoposte a check-up medici annuali tra il 2017 e il 2022. Di questi, circa 1440 avevano la steatosi epatica, diagnosticata tramite ecografia o TAC addominale.
Ebbene, la prima cosa che è saltata all’occhio è stata sorprendente: le persone con fegato grasso avevano, in media, un numero significativamente più alto di quasi tutti i tipi di linfociti nel sangue! Parliamo di:
- Linfociti B (CD19+)
- Cellule NK (CD16+56+)
- Linfociti T totali (CD3+)
- Linfociti T helper (CD4+)
- Linfociti T citotossici (CD8+)
- E anche molte delle loro sotto-popolazioni funzionali, di memoria e attivate (come CD4+CD28+, CD4+CD45RA−, CD8+CD28+, CD8+DR+, CD8+CD38+).
Questa tendenza rimaneva valida anche dopo aver “pulito” i dati tenendo conto di fattori come età, sesso e la presenza di altri problemi metabolici (ipertensione, diabete/glicemia alterata, iperlipidemia, obesità). Sembra proprio che la steatosi dia una sorta di “scossa” generale al sistema immunitario periferico, portando a un aumento numerico di queste cellule. Curiosamente, le percentuali relative dei vari sottotipi e il rapporto CD4/CD8 rimanevano abbastanza stabili, suggerendo più una proliferazione generale che un cambiamento radicale nella differenziazione cellulare.
Non siamo tutti uguali: Età e Genere contano eccome!
Approfondendo l’analisi, sono emerse differenze interessanti legate al sesso e all’età.
Negli uomini con steatosi, l’aumento riguardava praticamente tutte le sottopopolazioni di linfociti T che abbiamo misurato. Un quadro piuttosto generalizzato.
Nelle donne, invece, l’aumento era significativo ma più mirato, coinvolgendo principalmente i linfociti T CD4+CD28+, CD4+CD45RA− (memoria), CD8+ totali e CD8+DR+. Questo ci dice che il sistema immunitario maschile e femminile potrebbero reagire in modo leggermente diverso alla presenza di fegato grasso, forse per influenze ormonali o altri meccanismi ancora da chiarire.
E l’età? Anche qui, le cose cambiano. L’effetto della steatosi sull’aumento dei linfociti sembrava più marcato nei gruppi più giovani (< 45 anni e 45-65 anni). Nel gruppo degli over 65, le differenze tra chi aveva la steatosi e chi no erano meno evidenti, specialmente per le cellule NK e i linfociti T CD8+. Inoltre, analizzando solo le persone con steatosi, abbiamo confermato un fenomeno noto come immunosenescenza: con l’avanzare dell’età, si osserva una diminuzione fisiologica dei linfociti T “naïve” (nuovi) e di quelli funzionali (CD28+) o attivati (CD38+). È come se l’esercito perdesse un po’ delle sue reclute fresche e della sua reattività con il passare degli anni, e questo avviene anche in chi ha il fegato grasso.
E il Metabolismo? Certo che c’entra!
Come accennato, la steatosi va spesso a braccetto con altri disturbi metabolici. E anche questi lasciano il segno sui nostri linfociti!
- L’ipertensione sembra associata a un aumento delle cellule NK e dei linfociti T, in particolare dei CD4+ funzionali (CD28+) e di memoria (CD45RA−).
- Chi ha problemi di glicemia (diabete o pre-diabete) mostrava più linfociti B e meno cellule NK, con un trend simile all’ipertensione per i CD4+.
- L’iperlipidemia (grassi alti nel sangue) sembrava avere un impatto minore sui linfociti T, anche se tendeva ad aumentare i linfociti B.
- L’obesità, invece, aveva un effetto notevole, associata a un aumento sia dei linfociti T CD4+ che CD8+, specialmente delle popolazioni funzionali e di memoria/attivate. Questo conferma l’idea che l’obesità stessa sia uno stato infiammatorio che si riflette a livello sistemico.
Abbiamo anche notato che più disturbi metabolici una persona accumulava (oltre alla steatosi), più alti tendevano ad essere i livelli di certi linfociti T (CD4+, CD4+CD28+, CD4+CD45RA−, CD8+, CD8+CD28+, CD8+CD38+).
Un dato interessante riguarda i cosiddetti “magri con fegato grasso” (lean NAFLD), più comuni in Asia. Nel nostro studio, questi soggetti tendevano ad avere livelli più bassi di alcuni linfociti T (CD4+, CD4+CD28+, CD4+CD45RA−, CD8+) rispetto ai soggetti non magri con steatosi. È un’area ancora poco studiata, ma suggerisce che i meccanismi potrebbero essere diversi e merita approfondimenti, magari legati al microbioma intestinale o a un diverso equilibrio immunitario.

Uno sguardo al futuro (e qualche limite)
Cosa ci portiamo a casa da tutto questo? Beh, l’idea principale è che la steatosi epatica non è solo un problema confinato al fegato. È associata a cambiamenti misurabili nel nostro sistema immunitario a livello del sangue periferico. Questo aumento generalizzato dei linfociti potrebbe riflettere quello stato di infiammazione cronica di basso grado di cui parlavamo all’inizio.
Monitorare questi profili linfocitari potrebbe, in futuro, diventare uno strumento in più per:
- Valutare in modo più completo lo stato di salute di chi ha la steatosi.
- Stratificare il rischio: abbiamo usato un indice semplice (FIB-4) per stimare il rischio di fibrosi e abbiamo visto che chi era a rischio intermedio/alto tendeva ad avere, al contrario, meno linfociti T di alcuni tipi (tranne memoria CD4+ e attivati CD8+DR+). Questo è intrigante e suggerisce che l’infiammazione cronica potrebbe portare a un esaurimento o a un cambiamento funzionale del sistema immunitario nelle fasi più avanzate.
- Cercare indicatori non invasivi per predire la progressione della malattia (verso fibrosi, cirrosi o persino tumori).
Certo, il mio è stato uno studio retrospettivo, su una popolazione specifica (cinese, prevalentemente maschile) e basato su diagnosi di steatosi fatte con imaging (non biopsia, che è il gold standard ma invasiva). Non avevamo dati sulla gravità precisa della steatosi o follow-up a lungo termine. Quindi, ci vuole cautela e servono studi più ampi, su popolazioni diverse e con un disegno prospettico per confermare e approfondire questi risultati.

In conclusione, quello che emerge è un quadro affascinante: il fegato grasso “parla” con il nostro sistema immunitario, e le tracce di questa conversazione si trovano nel sangue. Capire meglio questo dialogo, tenendo conto di età, sesso e stato metabolico, potrebbe aprirci nuove strade per gestire meglio una condizione così diffusa e potenzialmente seria. Continuiamo a indagare!
Fonte: Springer
